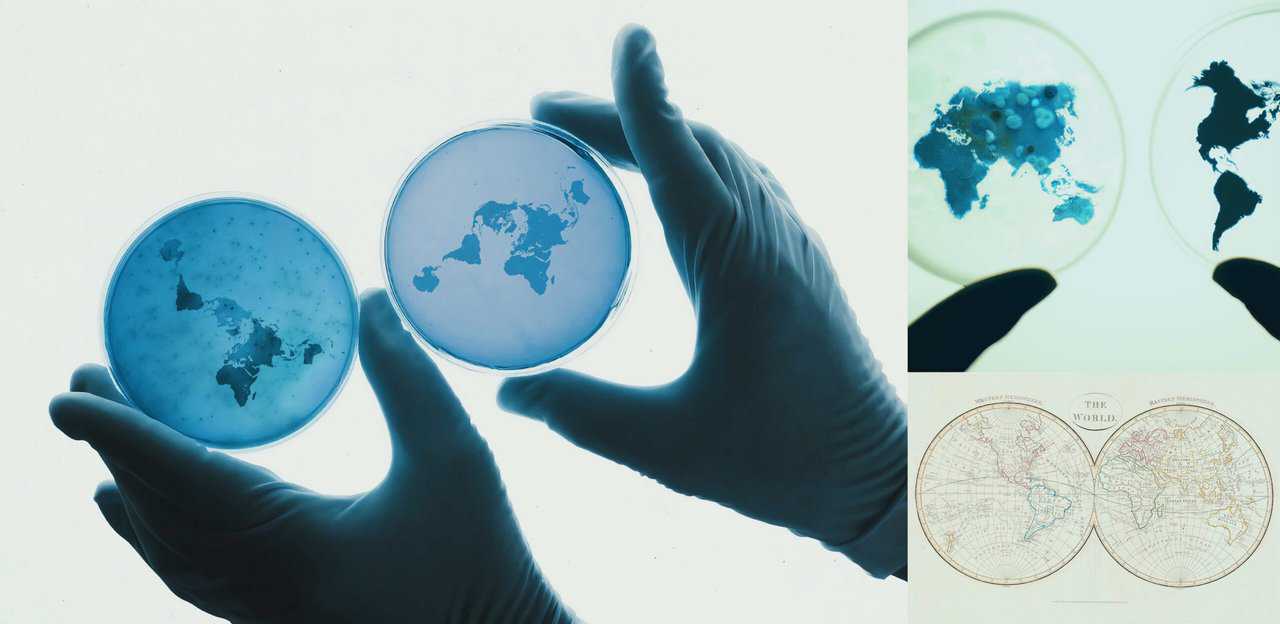

carnivorous coronavirus
the art of cartography
VIRUS IS A LANGUAGE FROM INNER SPACE
language is a virus from outer space.
William S. Burroughs
1 pixel represents 1 human on 1 planet. always.

minimal carbon video embed
minimal carbon video embed
minimal carbon video embed
minimal carbon video embed
minimal carbon video embed
minimal carbon video embed
immersive.earth MMXX